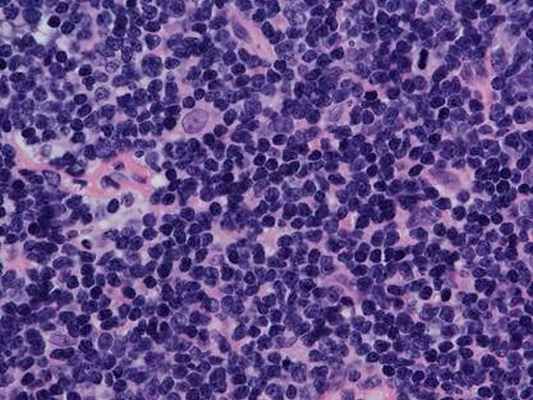
NL009

Патогенез неходжкинских лимфом и их классификация
Добавил пользователь Skiper Обновлено: 07.01.2026
Неходжкинская лимфома – это заболевание, при котором в лимфатической системе образуются злокачественные (раковые) клетки.
Лимфатическая система состоит:
Лимфа: бесцветная, водянистая жидкость, в которой содержатся лимфоциты. Лимфоциты защищают организм от инфекции. Лимфатические сосуды: сеть капилляров, собирающих лимфу из разных частей тела и возвращающих ее в кровоток.
Лимфатические узлы: небольшие, бобовидные структуры, которые фильтруют лимфу и сохраняют лейкоциты, которые помогают бороться с инфекцией и болезнями. Лимфатические узлы расположены вдоль сети лимфатических сосудов по всему телу. Кластеры лимфатических узлов расположены в области шеи, подмышек, брюшной полости, таза и паха.
Селезенка: орган, продуцирующий лимфоциты, фильтрующий кровь, сохраняет жизнеспособные клетки крови и разрушает старые клетки крови. Она находится в верхней левой части брюшной полости, позади желудка
Тимус: орган, в котором юные лимфоциты созревают до зрелых форм. Тимус находится в центре грудной клетке за грудиной.
Миндалины – это 6 небольших органов (парные небные, глоточная, язычная, парные трубные) расположенных в виде кольца на границе носоглотки и ротоглотки, состоящих из лимфатической ткани, выполняющие защитную и кроветворную функции, продуцируя лимфоциты.
Костный мозг: мягкая, губчатая ткань, расположенная в центре крупных костей. Костный мозг продуцирует большую часть лейкоцитов, эритроцитов и тромбоцитов.
Лимфатическая ткань также встречается и в других органах и тканях, таких как желудок, подвздошная кишка, аппендикс, щитовидная железа, мозг и кожа.
Существует три типа лимфоцитов:
B-лимфоциты, которые вырабатывают антитела, чтобы помочь бороться с инфекцией. Большинство типов неходжкинской лимфомы образовываются в В-лимфоцитах.
Т-лимфоциты, которые помогают В-лимфоцитам, образовывать антитела, которые помогают бороться с инфекцией. Также называются Т-клетками.
Природные клетки-киллеры, которые поражают раковые клетки и вирусы. Также называются NK-клетки.
Неходжкинская лимфома может образоваться в В-лимфоцитах, Т-лимфоцитах или естественных киллерных клетках. Лимфоциты находятся в крови, а также собираются в лимфатических узлах, селезенке и тимусе.
Основными типами лимфомы являются лимфома Ходжкина и неходжкинская лимфома.
Неходжкинская лимфома может быть индолентной или агрессивной.
Неходжкинская лимфома может встречаться как у взрослых, так и у детей. Схемы лечения взрослых отличается от схем лечения детей.
Неходжкинская лимфома растет и распространяется с разной скоростью и может быть индолентной или агрессивной.
Индолентная лимфома имеет тенденцию к медленному росту и распространению, и несколько признаков и симптомов.
Агрессивная лимфома, напротив, быстро растет и распространяется, имеет признаки и симптомы, которые могут быть серьезными. Лечение индолентной и агрессивной лимфомы различно.
Наличие некоторых факторов увеличивает риск развития некоторых типов неходжкинской лимфомы:
При наличии одного из следующих медицинских условий:
- Унаследованное иммунное заболевание (такое как гипогаммаглобулинемия или синдром Вискотта-Олдрича).
- Аутоиммунное заболевание (такое как ревматоидный артрит, псориаз или синдром Шегрена).
- ВИЧ / СПИД.
- Человеческий T-лимфотрофический вирус типа I или вирус Эпштейна-Барра.
- Helicobacter pylori.
- Постоянное получение иммунодепрессантов после трансплантации органов.
Признаки и симптомы неходжкинской лимфомы
Признаки и симптомы неходжкинской лимфомы включают: увеличение лимфатических узлов, лихорадку, ночные поты, потерю веса и усталость, однако эти симптомы могут быть вызваны не только неходжкинской лимфомой, но и другими заболеваниями.
Необходимо проконсультироваться с вашим врачом, если у вас есть один из следующих симптомов:
- Увеличение лимфатических узлов в области шеи, подмышек, паха или в области живота
- Лихорадка по неизвестной причине.
- Повторяющиеся ночные поты.
- Чувство усталости.
- Потеря веса по неизвестной причине.
- Кожная сыпь или зуд кожи.
- Боль в груди, животе или костях по неизвестной причине.
Другие признаки и симптомы неходжкинской лимфомы могут возникать и зависеть от следующих факторов:
- Локализация
- Размер опухоли.
- Как быстро опухоль растет.
Диагностические мероприятия, необходимые для обнаружения и диагностики неходжкинской лимфомы:
- Физический осмотр:
- УЗИ периферических лимфатических узлов, ОБП
- Компьютерная диагностика органов грудной и брюшной полости, малого таза
- Биопсия лимфатических узлов
- Аспирация костного мозга и биопсия: удаление костного мозга и небольшой кусочек кости путем вставки иглы в бедро или в грудную клетку.
- Иммуногистохимическое исследование: используются специальные антитела для проверки на наличие определенных антигенов в образце ткани. Антитело обычно связывается с радиоактивным веществом или красителем, который заставляет ткань загораться под микроскопом. Этот тип теста может быть использован для дифференциальной диагностики между различными типами рака.
- Цитогенетический анализ: лабораторный тест, в котором клетки в образце ткани просматриваются под микроскопом для поиска определенных изменений в хромосомах.
- FISH (флуоресценция in situ гибридизации): лабораторный тест, используемый для изучения генов или хромосом в клетках и тканях. Кусочки ДНК, содержащие флуоресцентный краситель, добавляются к клеткам или тканям на стеклянном слайде. Когда эти кусочки ДНК прикрепляются к определенным генам или участкам хромосом на слайде, они загораются при осмотре под микроскопом со специальным светом. Этот тип теста используется для поиска определенных генетических маркеров.
- Иммунофенотипирование: процесс, используемый для идентификации клеток на основе типов антигенов или маркеров на поверхности клетки. Этот процесс используется для диагностики конкретных типов лейкемии и лимфомы путем сравнения раковых клеток с нормальными клетками иммунной системы.
- ПЭТ-сканирование (позитронно-эмиссионная томография): процедура обнаружения злокачественных опухолевых клеток в организме. Небольшое количество радиоактивной глюкозы (сахара) вводится в вену. Сканер ПЭТ вращается вокруг тела и дает представление о том, где глюкоза используется в организме. Злокачественные опухолевые клетки проявляются ярче на снимке, потому что они более активны и потребляют больше глюкозы, чем нормальные клетки.
Другие тесты и процедуры могут проводиться в зависимости от выявленных признаков и симптомов, и локализации опухоли в организме.
Определенные факторы влияют на прогноз (вероятность выздоровления) и варианты лечения.
Прогноз (вероятность выздоровления) и варианты лечения зависят от следующего:
- Стадия рака.
- Тип неходжкинской лимфомы.
- Количество лактатдегидрогеназы (LDH) в крови.
- Существуют ли определенные изменения в генах.
- Возраст пациента и общее состояние здоровья.
- Является ли лимфома рецидивом
Существуют различные виды лечения пациентов с неходжкинской лимфомой: некоторые методы лечения являются стандартными (применяемое в настоящее время лечение), а некоторые из них все еще проходят клинические испытания. Способ назначения химиотерапии зависит от типа и стадии лечения рака.Лечение должно находиться под контролем онколога, гематолога, специализирующихся на лечении лимфопролиферативных заболеваний.
Химиотерапия – это вид лечения рака, который использует химиопрепараты для того, чтобы остановить рост раковых клеток, путем предотвращения их деления, и/или вызывать их гибель, различают системную и региональную химиотерапию: в случае парентерального и перорального введения химиопрепаратов, препараты сразу поступают в системный кровоток и могут поражать раковые клетки всего организма (системная химиотерапия), когда же химиопрепараты вводятся непосредственно в спинномозговой канал (интратекальная химиотерапия), орган или отдельную полость тела, препараты в основном воздействуют на раковые клетки в этих областях (региональная химиотерапия).
Моноклональная (таргетная) терапия – это лечение рака специальными антителами, полученными в лаборатории из одного типа клеток иммунной системы. Эти антитела могут идентифицировать определенные белки (рецепторы) на поверхности раковых клеток и нормальных клеток, и, в случае распознавания специфических рецепторов, прикрепляются к ним и уничтожают раковые клетки, блокируют их рост или не позволяют им распространяться.
Комбинированная химиотерапия – это лечение с использованием двух или более противоопухолевых препаратов. Стероидные препараты, не являющиеся химиопрепаратами, могут быть добавлены в схему лечения, чтобы уменьшить воспаление и снизить иммунный ответ организма.
Неходжкинские Лимфомы
Вам поставили диагноз: Неходжкинская лимфома?
Наверняка Вы задаётесь вопросом: что же теперь делать?
Подобный диагноз всегда делит жизнь на «до» и «после». Все эмоциональные ресурсы пациента и его родных брошены на переживания и страх. Но именно в этот момент необходимо изменить вектор «за что» на вектор «что можно сделать». Очень часто пациенты чувствуют себя безгранично одинокими вначале пути. Но вы должны понимать - вы не одни.
Предлагаем вашему вниманию краткий, но очень подробный обзор Неходжкинской Лимфомы.
Его подготовили высоко квалифицированные специалисты Отдела лекарственного лечения злокачественных новообразований МРНЦ имени А.Ф. Цыба и Отдела лекарственного лечения опухолей МНИОИ имени П.А. Герцена – филиалов ФГБУ «НМИЦ радиологии» Минздрава России под редакцией заведующих отделами, д.м.н. ФАЛАЛЕЕВОЙ Н.А. и д.м.н. ФЕДЕНКО А.А.
Филиалы и отделения, где лечат неходжкинские лимфома
МНИОИ им. П.А. Герцена – филиал ФГБУ «НМИЦ радиологии» Минздрава России.
Отдел лекарственного лечения опухолей
Заведующий отделом, д.м.н. ФЕДЕНКО Александр Александрович
тел: 8 (494) 150 11 22
МРНЦ им. А.Ф. Цыба – филиал ФГБУ «НМИЦ радиологии» Минздрава России.
Отдел лекарственного лечения злокачественных новообразований
Заведующая отделом, д.м.н. ФАЛАЛЕЕВА Наталья Александровна
тел: 8 (484) 399 – 31-30
Неходжкинские лимфомы
– Это историческое название, обозначающее, что данный тип лимфомы не является лимфомой Ходжкина. Неходжкинские лимфомы (НХЛ) – это большая группа опухолей лимфоидной системы, внутри которой выделяют наиболее часто встречающиеся В-клеточные лимфомы, возникшие из В-лимфоцитов и Т-клеточные лимфомы- из Т-лимфоцитов. НХЛ подразделяют на агрессивные и вялотекущие основываясь на характере течения опухоли, подходы к лечению вялотекущих и агрессивных лимфом разняться. Вялотекущие (индолентные) лимфомы на сегодняшний день неизлечимы. Благодаря их медленному развитию, иногда от момента установки диагноза до начала лечения проходит длительное время, исчисляемое годами. Агрессивные лимфомы следует лечить сразу после обнаружения, целью лечения в этих случаях является достижение ремиссии. Опухолевые клетки при агрессивных лимфомах делятся очень быстро, опухоль может стремительно увеличивать свои размеры, симптомы болезни возникают быстро.
К факторам, предрасполагающим развитию неходжкинских лимфом относиться:
· Вирус Эпштейн-Барр, Т-лимфотропный вирус человека, вирус герпеса 8 типа.
· Вирус гепатита С.
· Хроническая бактериальная инфекция: Helicobacter pylori, Borelliaburgdorferi.
· Прием лекарственных препаратов, подавляющих иммунитет.
Клиническая картина
Как правило, манифестация НХЛ сопровождается симптомами, которые носят общий характер, например- повышение температуры тела, общая слабость, повышенная утомляемость, потеря веса, суставные боли и т.д. Можно сказать, что злокачественное заболевание крови на начальных этапах может прятаться под «масками» других заболеваний. Не напрасно же среди гематологов существует профессиональная поговорка: «Лимфома – обезьяна любой болезни». В связи с наличием общих жалоб часто ошибочно устанавливаются неверные диагнозы, назначается симптоматическое лечение. В результате в гематологическую клинику пациент поступает лишь спустя время и уже в тяжелом состоянии, а диагноз устанавливается на поздней стадии, что ухудшает прогноз и течение заболевания, создает дополнительные терапевтические проблемы.
В типичном случае поражаются лимфатические узлы, их локализация крайне вариабельна и в незначительной степени зависит от варианта НХЛ. Симптомы болезни будут зависеть от расположения растущих лимфатических узлов. Довольно часто в опухолевый процесс вовлекаются селезенка и костный мозг. Поражение селезёнки проявляется тяжестью и дискомфортом в левой половине живота, вовлечение в процесс костного мозга можно заподозрить на основании анализа крови. Возможно поражение органов, не относящихся к лимфатической системе, например, желудок, легкие, головной мозг, молочная железа, яички, кости, кожа и т.д. при этом симптомы болезни будут соответствовать поражению органа. В этом случае речь идет о экстранодальном (=вне лимфатической системы) варианте НХЛ.
Диагноз
В настоящее время отличить один вариант лимфомы от другого возможно лишь при проведении комплексного иммуноморфологического исследования, подкрепленного в ряде случаев цитогенетическим и молекулярными анализами опухолевой ткани, взятой при биопсии. Выбор программы лечения, в том числе с применением новейших таргетных препаратов, также основывается на детальном изучении иммунологического и генетического портрета опухоли.
Обследование. См. раздел Лимфома Ходжкина.
Лечение неходжкинских лимфом
План лечения определяется в каждом случае индивидуально и зависит от иммуноморфологического варианта НХЛ, ее молекулярно-генетических особенностей, стадии заболевания, наличия факторов прогноза и общих симптомов.
Хирургический метод
В лечении лимфом практически не используется. С целью диагностики заболевания выполняется биопсия пораженного лимфатического узла или ткани.
«Наблюдай и жди»
При некоторых вариантах индолентных НХЛ, когда клинические проявления болезни минимальны, а состояние больного хорошее, лечение не начинается сразу после установления диагноза, пациент остается под наблюдением врача до наступления «симптомной» болезни. Такой подход возможен при фолликулярной лимфоме, лимфоме из клеток маргинальной зоны, при хроническом лимфолейкозе. Выжидательная тактика неприменима к агрессивным вариантам лимфом, когда лечение необходимо начинать сразу после установления диагноза.
Лекарственная терапия неходжкинских лимфом
Клетки лимфомы обычно обладают высокой чувствительностью к химиопрепаратам, причем тем более агрессивно ведет себя опухоль, тем, как правило, большей чувствительностью она обладает. Прогноз при НХЛ кардинально изменился за последние два десятилетия. Причиной тому стало развитие нового направления лекарственной терапии рака- таргетной, т.е. лечение с использованием препаратов направленного действия. Так, эффективность анти- CD20-антитела ритуксимаба при многих видах В-клеточных лимфом оказалась настолько высока, что время после начала применения препарата получило название «эра ритуксимаба».
Изучение иммунологических, биологических и функциональных свойств отдельных видов НХЛ привело к пониманию механизмов их возникновения и развития. Эти знания легли в основу создания самых современных программ лекарственного лечения каждого иммуноморфологического варианта лимфомы. Терапевтические программы сегодня – это, как правило, сочетание определенных режимов цитостатиков с новейшими таргетными препаратами. Использование указанных режимов позволяет достигать длительные и стойкие ремиссии даже при генерализованных стадиях лимфом.
Лучевая терапия неходжкинских лимфом
При лучевой терапии воздействие осуществляется непосредственно на пораженные лимфатические узлы и ткани организма, содержащие опухолевые клетки, которые чрезвычайно чувствительны к воздействию радиации. Индивидуальная программа лечения пациента обычно включает лекарственное лечение, которое проводится первым этапом и лучевую терапию обычно в качестве закрепляющего второго этапа.
В ряде случаев, после завершения двух этапов лечения пациенту назначается поддерживающеелечение, включающее в себя, как правило, таргетные иммунопрепараты.
Филиалы и отделения Центра, в которых лечат неходжкинскую лимфому
ФГБУ «НМИЦ радиологии» Минздрава России обладает всеми необходимыми технологиями лучевого, химиотерапевтического и хирургического лечения, включая расширенные и комбинированные операции. Все это позволяет выполнить необходимые этапы лечения в рамках одного Центра, что исключительно удобно для пациентов.
Отдел лекарственного лечения злокачественных новообразований МРНЦ имени А.Ф. Цыба – филиал ФГБУ «НМИЦ радиологии» Минздрава России
Заведующая отделом, д.м.н. ФАЛАЛЕЕВА Наталья Александровна
8 (484) 399 – 31-30, г. Обнинск, Калужской области
Отдел лекарственного лечения опухолей МНИОИ имени П.А. Герцена –филиал ФГБУ «НМИЦ радиологии» Минздрава России
Заведующий отделом, д.м.н. ФЕДЕНКО Александр Александрович
Неходжкинская лимфома

Неходжкинскими лимфомами (лимфосаркомой, НХЛ) называют злокачественные поражения лимфатической системы, которые не являются лимфомой Ходжкина. Это группа онкологических заболеваний, отличающихся между собой по степени злокачественности, скорости развития опухолевого процесса и имеющейся симптоматике. В основе патологии лежит злокачественная пролиферация В-лимфоцитов (реже Т-лимфоцитов). Опухоли могут формироваться в лимфоузлах, костном мозге, тканях селезенки и других органах.
Неходжкинская лимфома встречается чаще лимфогранулематоза (лимфомы Ходжкина). Болезнь выявляют во всех возрастных группах, однако чаще у людей старшего возраста. На 100 тыс. населения регистрируется 1-7 случаев патологии. По статистическим данным, около 4% новых онкологических диагнозов приходятся на НХЛ.
Заболевание развивается в условиях воздействия на организм онкогенных факторов или в случае подавления естественных механизмов антионкогенной защиты. Данные процессы ведут к нарушениям клеточного цикла лимфоцитов, в результате чего изменяется их морфология, свойства и функции. Атипичные клетки оседают в лимфатической системе, бесконтрольно делятся, формируя опухоли. Злокачественные клетки разносятся по организму вместе с лимфой и кровью, что сопровождается образованием метастазов.
Лимфомы, произрастающие в лимфатической ткани, называют нодальными. При локализации опухоли в других органах — экстранодальными. Ориентируясь на структуру, выделяют фолликулярные и диффузные лимфомы. В зависимости от скорости прогрессирования, опухоли могут быть индолентными (вялое развитие), агрессивными и высокоагрессивными.
Симптомы неходжкинской лимфомы
Неходжкинская лимфома может проявляться по-разному. Клиническая картина зависит от места расположения, гистологического типа и поведения первичной опухоли. Чаще всего заболевание сопровождается следующими симптомами:
- Увеличение лимфатических узлов. На начальных этапах лимфоузлы увеличиваются незначительно, остаются подвижными и не доставляют особого дискомфорта. На поздних стадиях отмечается их групповое поражение с образованием крупных конгломератов.
- Симптомы компрессии тканей. Увеличенные лимфоузлы могут сдавливать окружающие ткани с развитием дисфункции определенного органа. Это могут быть нарушения носового дыхания, глотания, отек лица, одышка, желтуха, боли в грудной клетке и брюшной полости и пр.
- Неспецифические проявления. Неходжкинская лимфома может провоцировать общие симптомы, которые невозможно отнести к заболеванию конкретного органа. Онкологическому процессу сопутствует беспричинная лихорадка, потливость, астения, сонливость, потеря веса и пр.
При экстранодальном расположении опухоли клинические проявления соответствуют дисфункции вовлеченного в патологический процесс органа. Например, лимфома желудка может провоцировать нарушения пищеварения, боли в эпигастральной области и внутренние кровотечения. Абдоминальные опухоли вызывают кишечную непроходимость, асцит, мальабсорбцию и перитонит. Поражение кожи проявляется узловатой эритемой в виде бугорков на коже, папул или бляшек.
Причины неходжкинской лимфомы
- наличие кровных родственников с лимфомами;
- врожденные и приобретенные иммунодефициты;
- терапия иммуносупрессорами;
- контакты с канцерогенными химическими веществами;
- аутоиммунные заболевания (ревматоидный артрит, аутоиммунный тиреоидит и пр.);
- хроническое воспаление в организме.
Получить консультацию
Если у Вас наблюдаются подобные симптомы, советуем записаться на прием к врачу. Своевременная консультация предупредит негативные последствия для вашего здоровья.
Узнать подробности о заболевании, цены на лечение и записаться на консультацию к специалисту Вы можете по телефону:

Почему «СМ-Клиника»?
Диагностика неходжкинской лимфомы
Подозрения в отношении заболевания возникают при безболезненном увеличении нескольких групп лимфатических узлов и наличии общих неспецифических симптомов дисфункции со стороны других органов. Основным методом диагностики является биопсия с последующим цитологическим, цитогенетическим и иммуногистохимическим анализом. Правильная верификация опухоли играет решающую роль при подборе терапевтической тактики. При точной постановке диагноза повышаются шансы достижения ремиссии.
Увеличение периферических и внутренних лимфоузлов определяют с помощью визуализационных диагностических процедур. В рамках первичной диагностики применяют ультразвуковое сканирование. С целью выявления метастазов и стадирования заболевания проводят МРТ внутренних органов и сцинтиграфию костей. В ряде случаев применяют эндоскопические методы.
Лабораторная диагностика включает общеклинические анализы, скрининг на инфекции с целью выявления факторов риска и биохимическое исследование крови для оценки функции внутренних органов.
Мнение эксперта
Успешность лечения онкологических заболеваний зависит от множества факторов. Это форма и стадия онкопроцесса, гистологический тип опухоли, состояние организма пациента и наличие сопутствующих патологий.
Важную роль играют и технологические возможности медицинского центра, а также квалификация онкологов. Персонифицированный подход и лечение неходжкинских лимфом в соответствии с последними научными разработками и международными протоколами способствуют достижению лучших прогнозов для пациента.
Врач-онколог, врач-гематолог, врач-радиолог (лучевой терапевт) высшей категории, д.м.н., профессор, отличник здравоохранения РФ, ведущий специалист
Лечение неходжкинской лимфомы
Лечение неходжкинской лимфомы проводится в онкогематологическом отделении. Терапевтическую тактику подбирают в индивидуальном порядке, ориентируясь на иммуноморфологический и генетический портрет опухоли. Если заболевание прогрессирует медленно и бессимптомно, может применяться выжидательная тактика.
Основными методами лечения НХЛ являются следующие:
- Химиотерапия. Подразумевает применение препаратов, которые подавляют активность опухоли.
- Лучевая терапия. Ионизирующее облучение применяется в целях разрушения опухоли при ограниченных формах заболевания.
- Иммунотерапия. Применяются препараты моноклональных антител, которые активизируют иммунитет организма против злокачественных клеток.
- Таргетная терапия. Подразумевает лечение препаратами, которые избирательно уничтожают клетки опухоли, не повреждая здоровые органы и ткани.
- Хирургия. Предполагает удаление лимфатических узлов при ограниченном поражении лимфатической системы. В некоторых случаях проводят трансплантацию костного мозга с целью восстановления нормального синтеза иммунных клеток.
НХЛ считается потенциально излечимой онкопатологией, однако прогнозы зависят от варианта течения болезни и вида опухоли. В настоящее время способы лечения неходжкинской лимфомы совершенствуются. Ранняя диагностика заболевания и комбинация различных методов терапии позволяют существенно продлить и улучшить качество жизни больного.
Специалисты медицинского центра «СМ-Клиника» успешно проводят диагностику и лечение неходжкинской лимфомы. С целью верификации диагноза применяются наиболее современные методы диагностики. Все исследования можно пройти в комфортных условиях и за короткие сроки в условиях нашего Центра. Лечение подбирается в соответствии с последними международными рекомендациями. В клинике используются наиболее современные методы с доказанной эффективностью.
Лимфомы
Лимфома- это разнородная группа онкологических заболеваний лимфатической ткани, характеризующееся увеличением лимфатических узлов и/или поражением различных внутренних органов, в которых происходит бесконтрольное накопление "опухолевых" лимфоцитов.
Лимфоцит- клетка крови, являющаяся главным компонентом иммунной системы организма. При лимфоме в результате бесконтрольного деления "опухолевых" лимфоцитов их потомки заселяют лимфатические узлы и различные внутренние органы, вызывая нарушение их нормальной работы. Термином "лимфома" обозначают большое количество различных видов заболевания, существенно отличающихся друг от друга по своим проявлениям и подходам к их лечению. Все лимфомы разделяют на 2 большие группы: лимфогранулематоз (другое название болезнь Ходжкина) и неходжкинские лимфомы.
СИМПТОМЫ ЛИМФОМ
Как правило, первым симптомом лимфомы является значительное увеличение размеров лимфатических узлов на шее, в подмышечных впадинах или в паху. При этом, в отличие от инфекционных заболеваний, увеличенные лимфатические узлы безболезненны, их размеры не уменьшаются со временем и при лечении антибиотиками. Иногда, вследствие давления со стороны увеличенных печени, селезенки и лимфатических узлов, возникает чувство переполнения в животе, затруднения дыхания, распирающие боли в нижней части спины, ощущение давления в лице или на шее.
Другими симптомами, встречающимися при лимфоме, являются:
- Слабость
- Повышение температуры тела
- Потливость
- Потеря веса
- Нарушения пищеварения
ДИАГНОСТИКА ЛИМФОМ
Чтобы поставить диагноз лимфомы необходимо пройти обследование у специалистов. Традиционно лимфомами занимаются врачи-онкологи и врачи-гематологи.
Лабораторная диагностика.Основным анализом, позволяющим подтвердить диагноз лимфомы, является микроскопическое исследование образца лимфоидной ткани, полученной при биопсии (хирургическом удалении лимфатического узла или кусочка ткани пораженного органа). Эта ткань направляется на морфологическое исследование к врачу-патоморфологу, главной задачей которого является определить: "Есть ли в изучаемой ткани опухолевые (лимфомные) клетки?" Если врач находит опухолевые (лимфомные) клетки в изучаемом гистологическом препарате, то следующий вопрос, который он должен решить: "С каким видом лимфомы мы имеем дело?"
Исследование костного мозгатакже проводится с целью установить: "Есть ли опухолевые (лимфомные) клетки в костномозговой ткани?" Дополнительные методы исследования позволяют уточнить ряд особенностей лимфомы. К ним относятся иммунофенотипирование методом проточной цитометрии, цитогенетические и молекулярно-генетические исследования.
Лучевая диагностика(рентгенологическое исследование, компьютерная, магнитно-резонансная томография) позволяет выявить наличие опухолевых образований в различных частях тела, которые не доступны врачу при внешнем осмотре. Методы лучевой диагностики применяют для определения стадии лимфомы.
ВИДЫ ЛИМФОМЫ
Термином неходжкинские лимфомы обозначают довольно большую группу лимфом, которые не являются болезнью Ходжкина (лимфогранулематозом). Решение о принадлежности лимфомы к группе неходжкинских лимфом или к болезни Ходжкина принимается после гистологического исследования образца биопсированной ткани. Если при микроскопическом исследовании находят специфические для болезни Ходжкина клетки Березовского-Штернберга-Рида, то ставят диагноз болезни Ходжкина. Если эти специфические клетки не находят, то лимфому относят к группе неходжкинских.
Неходжкинские лимфомы имеют много подвидов, которые отличаются по гистологической картине, клиническим проявлениям и подходам к их лечению. Одни виды лимфом имеют медленное и благоприятное течение, порой длительное время не требуют специального лечения. Такие лимфомы называют индолентными. Ряд других лимфом, напротив, характеризуются быстрым прогрессированием, большим количеством симптомов и требуют немедленного начала лечения. Такие лимфомы называют агрессивными. Встречаются лимфомы с промежуточными характеристиками. Чаще всего аномальный рост лимфоцитов начинается в лимфатических узлах, при этом развивается классический вариант лимфомы, сопровождающийся увеличением лимфатических узлов. Однако встречаются лимфомы, при которых лимфатические узлы не увеличиваются, т.к. заболевание первично возникает не в лимфатическом узле, а в различных органах: селезенке, желудке, кишке, легких головном мозге. Такие лимфомы называют экстранодальными.
Долгое время во многих странах существовали различные классификации, включающие разные названия и термины для обозначения одного и того же вида неходжкинских лимфом, что создавало большие трудности, как для врачей, так и для пациентов. В 2001 международное сообщество выработало единые подходы к классификации лимфом, и была принята единая, так называемая классификация Всемирной организации здравоохранения (ВОЗ), которой сегодня пользуются в большинстве стран мира.
Мы представляем 4-ую редакцию классификации ВОЗ (2008) в полном объеме. При желании каждый может ознакомиться с ней настолько, насколько считает для себя необходимым.
Классификация неходжкинских лимфом Всемирной организации здравоохранения
В-клеточные опухоли из предшественников В-лимфоцитов:
- В-лимфобластная лимфома / лейкоз из клеток-предшественников (В-клеточный острый лимфобластный лейкоз из клеток-предшественников).
В-клеточные опухоли из периферических (зрелых) В-лимфоцитов:
- Хронический лимфоцитарный лейкоз / лимфома из малых лимфоцитов (лимфоцитарная лимфома)
- В-клеточный пролимфоцитарный лейкоз
- Лимфоплазмоцитарная лимфома
- Селезеночная лимфома маргинальной зоны (+/- ворсинчатые лимфоциты)
- Волосатоклеточный лейкоз
- Лимфоплазмоцитарная лимфома
- Болезни тяжелых цепей
- Плазмоклеточная миелома/плазмоцитома
- Экстранодальная В-клеточная лимфома маргинальной зоны MALT-типа
- Нодальная В-клеточная лимфома маргинальной зоны (+/- моноцитоидные В- лимфоциты)
- Фолликулярная лимфома
- Лимфома из клеток мантийной зоны
- Диффузная В-крупноклеточная лимфома
- Медиастинальная диффузная В-крупноклеточная лимфома
- Первичная экссудативная лимфома
- Лимфома / лейкоз Беркитта
Т- и NK-клеточные опухоли из предшественников Т-лимфоцитов
- Т-лимфобластная лимфома/лейкоз из клеток-предшественников (Т-клеточный острый лимфобластный лейкоз из клеток-предшественников)
Т-клеточные лимфомы из периферических (зрелых) Т-лимфоцитов:
- Т-клеточный пролимфоцитарный лейкоз
- Т-клеточный лейкоз из больших гранулярных лимфоцитов
- Агрессивный NK-клеточный лейкоз
- Т-клеточная лимфома / лейкоз взрослых (HTLV1+)
- Экстранодальная NK/T-клеточная лимфома, назальный тип
- Т-клеточная лимфома, ассоциированная с энтеропатией
- Гепатолиенальная Т-клеточная лимфома
- Т-клеточная панникулитоподобная лимфома подкожной клетчатки
- Грибовидный микоз / синдром Сезари
- Анапластическая крупноклеточная лимфома, Т/0-клеточная, с первичным поражением кожи
- Периферическая Т-клеточная лимфома, неуточненная
- Ангиоиммунобластная Т-клеточная лимфома
- Анапластическая крупноклеточная лимфома, Т/0-клеточная, с первичным системным поражением
СТАДИИ ЛИМФОМЫ
Определение стадии лимфомы помогает понять степень распространенности заболевания. Это важная информация для принятия правильного решения в отношении программы лечения. Подходы к лечению начальных (местных) стадий и распространенных стадий лимфом обычно отличаются. При избрании программы лечения учитывают не только стадию, но и многие другие факторы: вид лимфомы, результаты дополнительных исследований (цитогенетических, иммунологических, молекулярных др.), состояние больного, его возраст, сопутствующие заболевании и т.д. Тем не менее, информация о стадии заболевания чрезвычайно важна для разработки эффективной программы лечения.
В соответствии с общепринятой международной классификацией (ее называют классификацией Анн-Арбор по названию города в США, где она была принята) выделяют 4 стадии заболевания: I-ю, II-ю, III-ю и IV-ю. К номеру стадии обычно добавляют буквы А или Б. С помощью этих букв указывают на наличие или отсутствие 3-х важных симптомов, которые могут встречаться у больных лимфомой: лихорадки, выраженной ночной потливости и снижение веса. Если используют букву А - это означает, что вышеуказанные симптомы отсутствуют, если используют букву Б - это говорит о наличии у больного вышеуказанных симптомов.
В классификации выделено четыре стадии заболевания, которые могут быть условно обозначены как местные (локальные, ограниченные) - I-я и II-я стадии и распространенные - III-я и IV-я стадии.
I-я стадия- допускается вовлечение в лимфомный процесс одной области лимфатических узлов
II-я стадия- допускается вовлечение в процесс двух и более областей лимфатических узлов с одной стороны диафрагмы (диафрагма - это мышечный листок, который разделяет грудную клетку и брюшную полость).
III-я стадия- допускается поражение лимфатических узлов с обеих сторон диафрагмы.
IV-я стадия- заболевание распространяется помимо лимфатических узлов на внутренние органы: сердце, печень, почки, кишку, костный мозг и др.
ЛЕЧЕНИЕ ЛИМФОМЫ
Выбор программы лечения зависит от вида лимфомы и состояния больного.
- Индолентные лимфомы в отдельных случаях могут не требовать лечения, достаточным является наблюдение врача (гематолога или онколога). Однако появление первых признаков прогрессирования заболевания: увеличения лимфатических узлов, усиления слабости, повышения температуры тела и др. являются сигналом для начала лечения. При местно распространенных стадиях часто используют радиотерапию - облучение пораженных опухолью лимфатических узлов. При генерализованных стадиях предпочтение отдают химиотерапии. Спектр возможных препаратов для лечения индолентных лимфом достаточно велик: хлорбутин, флударабин, циклофосфан, винкристин, ритуксимаб и др. Индолентные лимфомы относятся к заболеваниям, полное излечение которых сегодня представляется маловероятным. Основной целью лечения индолентных лимфом считают увеличение продолжительности и улучшение качества жизни больного.
- Агрессивные лимфомы, как правило, требуют немедленного начала лечения. Одной из наиболее распространенных программ химиотерапии является программа CHOP в сочетании с применением моноклонального антитела Ритуксимаб.
- Высоко агрессивные лимфомы лечатся по программам химиотерапии для острых лимфобластных лейкозов или сходных с ними. Целью лечения агрессивных и высокоагрессивных лимфом является излечение. Однако, это возможно не во всех случаях.
- Одной из эффективных программ лечения агрессивных и высокоагрессивных лимфом является высокодозная химиотерапия с трансплантацией кроветворных стволовых клеток.
© 2022 ФГБУ «НМХЦ им. Н.И. Пирогова» Минздрава России. Использование материалов сайта полностью или частично без письменного разрешения строго запрещено.
Неходжкинские лимфомы
Неходжкинские лимфомы лечение, симптомы, признаки, прогноз.
Содержание:
Лимфомы – это вид злокачественных опухолей, которые поражают лимфатическую систему. Неходжкинские лимфомы включают в себя все лимфомы, кроме лимфомы Ходжкина. Эта группа заболеваний очень неоднородна и включает в себя очень разные по характеру течения, по своему строению и характеристикам.

В структуре онкологической заболеваемости доля неходжкинских лимфом (лимфосарком) составляет примерно 3 %. В Беларуси этот показатель несколько ниже.
Стоит отметить, что за последние 10 лет наблюдается увеличение заболеваемости НХЛ во многих странах мира, в том числе и в Беларуси. Если в 2001 год наблюдалось 470 случаев, то в 2010 году уже 638, т.е. заболеваемость выросла в 1,4 раза.
Как возникает неходжкинская лимфома?
В настоящее время считается, что лимфома возникает, когда здоровые лимфатические клетки по разным причинам останавливают свое развитие на различных этапах. Из них формируются опухолевые клетки различных типов лимфом.
Лимфомы, возникающие из Т- и В-линий лимфоцитов, а также из клеток различной степени дифференцировки, имеют уникальный набор антигенов (иммунофенотип). Определение иммунофенотипа наряду с определением морфологических характеристик широко используется в диагностике. Эта процедура осуществляется при помощи панели диагностических моноклональных антител.
Причины возникновения неходжкинских лимфом
На данный момент причины возникновения большинства видов неходжкинских лимфом остаются неясными, но для некоторых форм лимфом установлена связь с различными факторами.
1. Снижение иммунитета (иммунодефицит)
Значительно повышен риск развития заболевания при иммунодефицитных состояниях различной природы (включая ВИЧ-инфекцию, ряд аутоиммунных заболеваний и наследственных синдромов с иммунодефицитной составляющей и др.).
2. Вирусные заболевания
В ряде случаев доказана роль вирусов в развитии лимфосарком – вируса Эпштейн-Барр для эпидемической лимфомы Беркитта, а также вируса Т-клеточной лейкемии/лимфомы в развитии ряда Т-клеточных лимфом с эндемическим характером распространения.
3. Некоторые бактериальные инфекции
Важным фактором риска развития MALT-лимфомы желудка в настоящее время считают кампиллобактериоз. Подтверждением этому служит то, что антибактериальное лечение, направленное против Helicobacter pylori, во многих случаях (до 70 %) вызывает регрессию лимфомы желудка.
4. Внешнее воздействие
Ряд физических и химических факторов также может способствовать развитию неходжкинских лимфом.
- факторы окружающей среды (ионизирующая радиация, диоксин);
- лекарственные препараты (цитостатическая терапия);
- лучевая терапия.
Диагностика и симптомы неходжкинской лимфомы
Во время диагностики, прежде всего, исследуется уникальный иммунофенотип злокачественных клеток. Это исследование проводится с помощью имуннологических методов и позволяет установить линейную принадлежность клеток (Т- или В-), а также степень их дифференцировки (предшественники или зрелые клетки).
К сожалению, выявить лимфосаркому на ранней стадии удается редко.
Чаще всего первым симптомом является увеличение лимфатических узлов, но т.к. это заболевание может протекать по-разному и с различными симптомами, оно может выявляться врачами самых разных специальностей.
При индолентных лимфосаркомах отмечается медленное увеличение нескольких групп лимфатических узлов.
Более агрессивные лимфомы (лимфота Беркитта, лимфобластная лимфома) прогрессируют очень быстро и общие симптомы появляются раньше.
Также симптомы зависят от локализации опухоли. Например, первым проявлением лимфомы тонкой кишки может стать кишечная непроходимость или перфорация стенки кишки.
Лимфома может быть диагностирована при:
- биопсии миндалины;
- при гастроскопии;
- исследовании ЦНС;
- дерматологом при биопсии кожи;
- при выполнении общего анализа крови.
Потеря массы тела, лихорадка неясного происхождения, необъяснимое ухудшение общего состояния также могут быть первыми симптомами неходжкинской лимфомы.
Течение заболевания

Прогрессирование лимфомы в значительной мере определяется морфологией и иммунологией клетки, положившей начало опухолевому росту.
Так, если клетка трансформировалась в злокачественную на раннем этапе своего развития и не успела покинуть костный мозг, то в результате имеется картина преимущественно костно-мозговых опухолей (острый лимфобластный лейкоз, лимфобластная лимфома).
В тех случаях, когда родоначальницей опухолевого клона становится более зрелая клетка лимфоидного ряда, в процессе созревания покинувшая костный мозг, поражение исходно локализуется в периферических лимфоидных органах и характеризуется более благоприятным течением.
Виды неходжкинских лимфом

Индолентные лимфомы отличаются, как правило, медленным ростом, длительным течением (годами), а также тем, что излечение больных практически невозможно даже в случаях достижения полной регрессии опухоли.
Агрессивные лимфомы (промежуточной и высокой степени злокачественности) характеризуются быстрым ростом, низкой выживаемостью в отсутствие лечения (месяцы и даже недели), высокой чувствительностью к химиолучевым воздействиям и возможностью излечения у значительного числа больных.
Неходжкинская лимфома лечение

Тактика лечения больных НХЛ зависит от вида опухоли, ее локализации.
Основным методом лечения неходжкинских лимфом является химиотерапия и лучевая терапия.
Лечение проводится короткими курсами с интервалом 2-3 недели.
В ходе лечения наблюдают реакцию опухоли на препараты, оценивают ее регрессию и при необходимости корректируют режим лечения.
Хирургическое лечение применяют очень ограниченно и только при определенных типах лимфом (например, при лимфомах желудочно-кишечного тракта), но даже в этих ситуациях его дополняют другими методами.
Развитие молекулярной биологии, революционно расширившее наши представления о развитии лимфом и наши диагностические возможности, в значительно меньшей мере повлияли на терапевтические подходы.
В настоящее широко применяяется лишь один ритуксимаб (антиCD20) в лечении В-клеточных лимфом.
Длительное течение индолентных лимфом и отсутствие симптомов (исключая лимфаденопатию) у большинства больных на момент постановки диагноза делают возможной выжидательную тактику.
Лечение начинают при появлении клинической симптоматики (симптомов интоксикации или симптомов, связанных с локальным ростом/инвазией опухолевых узлов).
Лечение химиотерапией требует обязательной реабилитации, соблюдения диеты и режима отдыха.
В случаях, когда имела место быть высокодозная химиотерапия проводят трансплантацию стволовых гемопоэтических клеток.
Читайте также:
